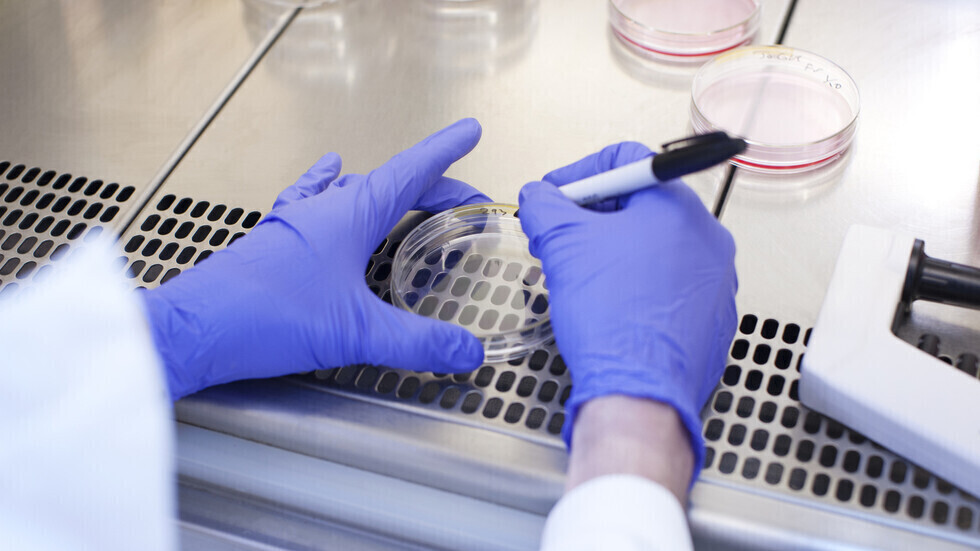
تحديد الجينات المسببة لسرطان نادر يصيب مواضع متنوّعة من الجسم

Stories
-
العملية العسكرية الروسية في أوكرانيا
RT STORIES
الدفاع الروسية: استعادة 205 جنود روس من الأسر الأوكراني بوساطة إماراتية
#اسأل_أكثر #Question_MoreRT STORIES
مقتل ثلاثة مدنيين وإصابة 12 آخرين بهجوم أوكراني على مقاطعة ريازان الروسية (صور)
#اسأل_أكثر #Question_MoreRT STORIES
كشفتها روسيا منذ سنوات.. مختبرات بيولوجية أمريكية في أوكرانيا ضمن ملفات إبستين وواشنطن تفتح تحقيقا
#اسأل_أكثر #Question_MoreRT STORIES
بيسكوف: نظام كييف "ألقى أوكرانيا في الكارثة" ولاذ بالصمت إزاء المأساة
#اسأل_أكثر #Question_MoreRT STORIES
هجوم أوكراني على منطقة قريبة من محطة زابوروجيه الكهروذرية يسفر عن إصابات
#اسأل_أكثر #Question_MoreRT STORIES
المستشار ميرتس: أوروبا ستختار بنفسها وسيطا للحوار مع روسيا
#اسأل_أكثر #Question_MoreRT STORIES
الكرملين: أوروبا تشارك فعليا في النزاع الأوكراني
#اسأل_أكثر #Question_More
العملية العسكرية الروسية في أوكرانيا
-
نبض الملاعب
RT STORIES
جماهير ريال مدريد تصب غضبها على مبابي وفينيسيوس بعد الموسم الكارثي (فيديو)
#اسأل_أكثر #Question_MoreRT STORIES
تحذيرات صحية خطيرة تهدد نجوم مونديال 2026
#اسأل_أكثر #Question_MoreRT STORIES
وفاة أول بطل في عالم القتال اليدوي
#اسأل_أكثر #Question_MoreRT STORIES
ديشان يعلن عن القائمة النهائية لمنتخب فرنسا في كأس العالم 2026
#اسأل_أكثر #Question_MoreRT STORIES
لرفعه علم فلسطين.. وزير الدفاع الإسرائيلي يهاجم لامين جمال ويتقدم بطلب لنادي برشلونة
#اسأل_أكثر #Question_MoreRT STORIES
الهلال السوداني يصبح أول فريق في العالم يفوز بلقب الدوري في 3 دول مختلفة
#اسأل_أكثر #Question_MoreRT STORIES
مدرب ليفربول يزف خبرا سارا لمشجعي صلاح
#اسأل_أكثر #Question_More
نبض الملاعب
-
زيارة ترامب إلى الصين
RT STORIES
تاكايتشي تسعى لاتصال عاجل بترامب لاستيضاح تفاصيل قمة بكين
#اسأل_أكثر #Question_MoreRT STORIES
بعد التحذير من "فخ ثوسيديدس".. بكين تؤكد التوصل إلى توافق مهم مع واشنطن جراء زيارة ترامب
#اسأل_أكثر #Question_MoreRT STORIES
ترامب: الولايات المتحدة أبرمت اتفاقيات تجارية "رائعة" مع الصين
#اسأل_أكثر #Question_MoreRT STORIES
"سي إن إن" تكشف احتياطات أمنية اتخذها الوفد الأمريكي قبل ذهابه إلى الصين لتفادي "مخاطر سيبرانية"
#اسأل_أكثر #Question_MoreRT STORIES
روبيو: السياسة الأمريكية لم تتغير واستيلاء الصين على تايوان بالقوة سيكون خطأ مروعا
#اسأل_أكثر #Question_MoreRT STORIES
شي جين بينغ مرحبا بترامب: "التجديد الصيني وMAGA يسيران يدا بيد"
#اسأل_أكثر #Question_MoreRT STORIES
البيت الأبيض: ترامب وشي يتفقان على إبقاء هرمز مفتوحا ومنع إيران من امتلاك السلاح النووي
#اسأل_أكثر #Question_MoreRT STORIES
ترامب: المحادثات مع شي جين بينغ سارت بشكل "ممتاز"
#اسأل_أكثر #Question_MoreRT STORIES
وفد أمريكي رفيع من رجال الأعمال يرافق ترامب في زيارته إلى الصين وبكين ترحب
#اسأل_أكثر #Question_More
زيارة ترامب إلى الصين
-
إسرائيل تواصل غاراتها على لبنان
RT STORIES
مصادر لـ"الأخبار": واشنطن وإسرائيل تتفقان على انسحاب تدريجي من لبنان قد يمتد عامين
#اسأل_أكثر #Question_MoreRT STORIES
رئيس مجلس النواب اللبناني: أنا "متشائل" من جولة المفاوضات في واشنطن
#اسأل_أكثر #Question_MoreRT STORIES
واشنطن تصف محادثات إسرائيل ولبنان بأنها "إيجابية ومثمرة"
#اسأل_أكثر #Question_MoreRT STORIES
الجيش الإسرائيلي: مقتل جندي في معركة في جنوب لبنان
#اسأل_أكثر #Question_MoreRT STORIES
الجيش الإسرائيلي: اعترضنا صواريخ أطلقت من جنوب لبنان باتجاه الشمال
#اسأل_أكثر #Question_MoreRT STORIES
مراسلة RT: إسرائيل تقصف مناطق في جنوب لبنان بالفوسفوري (فيديو)
#اسأل_أكثر #Question_MoreRT STORIES
حزب الله: السلطة مستمرة بتأرجحها الانحداري أمام غطرسة إسرائيل
#اسأل_أكثر #Question_MoreRT STORIES
وزير الدفاع الإسرائيلي: علينا إتمام المهمة في لبنان ونتعامل مع خطر الطائرات المسيرة
#اسأل_أكثر #Question_MoreRT STORIES
نزوح عشرات العائلات من البقاع الغربي وجنوب لبنان عقب التهديدات الإسرائيلية
#اسأل_أكثر #Question_MoreRT STORIES
فيديو يوثق حجم الدمار جراء غارة إسرائيلية في بلدة تفاحتا
#اسأل_أكثر #Question_More
إسرائيل تواصل غاراتها على لبنان
-
هدنة وحصار المضيق
RT STORIES
الخارجية الصينية: لا يوجد سبب لاستمرار الصراع في إيران
#اسأل_أكثر #Question_MoreRT STORIES
ترامب: الرئيس الصيني عرض المساعدة في إنهاء صراع إيران وإعادة فتح هرمز
#اسأل_أكثر #Question_MoreRT STORIES
كاتس: مهمتنا في إيران لم تنتهِ ونستعد للعودة إلى الهجوم قريبا إذا لزم الأمر
#اسأل_أكثر #Question_More
هدنة وحصار المضيق
أعراض غير معروفة للسرطان يمكن أن تحدث عند تناول الطعام
يعد سرطان المريء سادس أكثر أسباب الوفيات الناجمة عن السرطان شيوعا في جميع أنحاء العالم، بحسب مؤسسة "مايو كلينك".
ويساعد المريء، أو كما يعرف بأنبوب الطعام الذي يمتد من البلعوم إلى المعدة، على نقل الطعام الذي نبتلعه من مؤخرة الحلق إلى المعدة ليتم هضمه.

بينها السرطان .. حالات طبية مقلقة قد تكون "رائحة الفم الكريهة" علامة لها
يبدأ سرطان المريء عادة في الخلايا التي تبطن المريء من الداخل. ويمكن أن يحدث السرطان في أي مكان على طول المريء.
ويصاب الرجال بهذا السرطان أكثر من النساء. ولا يُعرف السبب الدقيق لسرطان المريء، لكن التدخين وشرب الكحول والسمنة والنظام الغذائي غير الصحي يمكن أن يزيد من خطر الإصابة.
ويمكن أن تظهر بعض العلامات التي تشير إلى الإصابة بسرطان المريء، عند تناول الطعام. وبحسب مؤسسة أبحاث السرطان في المملكة المتحدة تتمثل هذه العلامات في ثلاثة أعراض:
صعوبة في البلع
يُعرف أيضا باسم عسر البلع، ويظهر عند تناول الطعام أو الشرب.
وهناك نوعان من عسر البلع: عسر البلع الفموي الذي يصيب الفم أو الحلق، وعسر البلع الذي يؤثر على أنبوب الطعام.
ويمكن أن يؤدي عسر البلع إلى السعال أو الاختناق عند الأكل أو الشرب ويمكن أن يشعر الشخص أيضا بأن الطعام عالق في حلقه أو صدره.
يمكن أن يكون سيلان اللعاب المستمر علامة أيضا. ويعد عدم القدرة على مضغ الطعام بشكل صحيح والصوت الخشن عند الأكل أو الشرب من بين علامات هذا العارض.
عسر الهضم المستمر وحرقة المعدة

"العلامات المبكرة" لسرطان الفم أحدها يمكن ملاحظته في الصوت
إذا كنت تعاني من حرقة المعدة في معظم الأيام لمدة ثلاثة أسابيع أو أكثر، فيجب عليك طلب المشورة الطبية، وفقا لهيئة الخدمات الصحية.
ويمكن أن تكون مشاعر عسر الهضم علامة منذرة، وهي حالة تتمثل في الألم أو الانزعاج في الجزء العلوي من البطن (عسر الهضم) أو ألم حارق خلف عظم الصدر.
وقد يتم إعادة الطعام بعد هذه الأعراض، أحيانا عن طريق الأنف، مثل ارتجاع المريء.
ويسبب هذا طعما كريها وحامضا في الفم والجهاز الأنفي. وقد تحدث كلتا الأعراض معا أو من تلقاء نفسها، عادة بعد وقت قصير من الأكل أو الشرب.
فقدان الوزن غير المبرر
إلى جانب فقدان الشهية، يمكن أن يكون فقدان الوزن غير المبرر علامة على الإصابة بسرطان المريء.
وما يقرب من نصف المصابين يعانون من هذه الأعراض، والتي يمكن أن تكون بسبب تناول كميات أقل من الطعام بسبب صعوبة البلع.
ويأتي فقدان الوزن نتيجة لانخفاض السعرات الحرارية. وقد يجد الشخص صعوبة في البلع أو يشعر بالألم عند ابتلاع طعامه، ما يعني أنه يأكل أقل وبالتالي ينخفض وزنه.
تحديد الجينات المسببة لسرطان نادر يصيب مواضع متنوّعة من الجسم
ألم في الحلق أو خلف عظم القص
بالإضافة إلى المعاناة من صعوبة البلع، يمكن أن تكون عملية البلع مؤلمة أيضا، ويمكن أن يظهر هذا الألم كإحساس حارق يمكن الشعور به أيضا خلف عظمة الصدر.
كما يمكن أيضا الشعور بالألم في الظهر أو خلف عظام الصدر أو بين لوحي الكتف. وقد يزداد هذا سوءا عند البلع أو عند الإصابة بعسر الهضم.
وتشمل الأعراض الأخرى عودة الطعام، والسعال الذي لا يختفي، وبحة في الصوت، وسعال مصحوب بدم وبراز داكن.
وإذا واجه أي شخص أيا من هذه الأعراض بشكل مستمر أو رأى أنها تزداد سوءا، فيجب زيارة الطبيب.
ويشار إلى أن هذه العلامات قد تكون ناتجة عن عدة حالات أخرى لا تتعلق بالسرطان، ولذلك سيكون من المفيد إجراء الفحوصات اللازمة إذا كنت قلقا.
المصدر: ذي صن
إقرأ المزيد
طريقة ثورية للكشف المبكر عن سرطان البلعوم الفموي الحليمي
ذكرت مجلة Journal of the National Cancer Institute أن فريقا من العلماء نجح في ابتكار وسيلة جديدة للكشف المبكر عن سرطان البلعوم الفموي الحليمي.
التعليقات